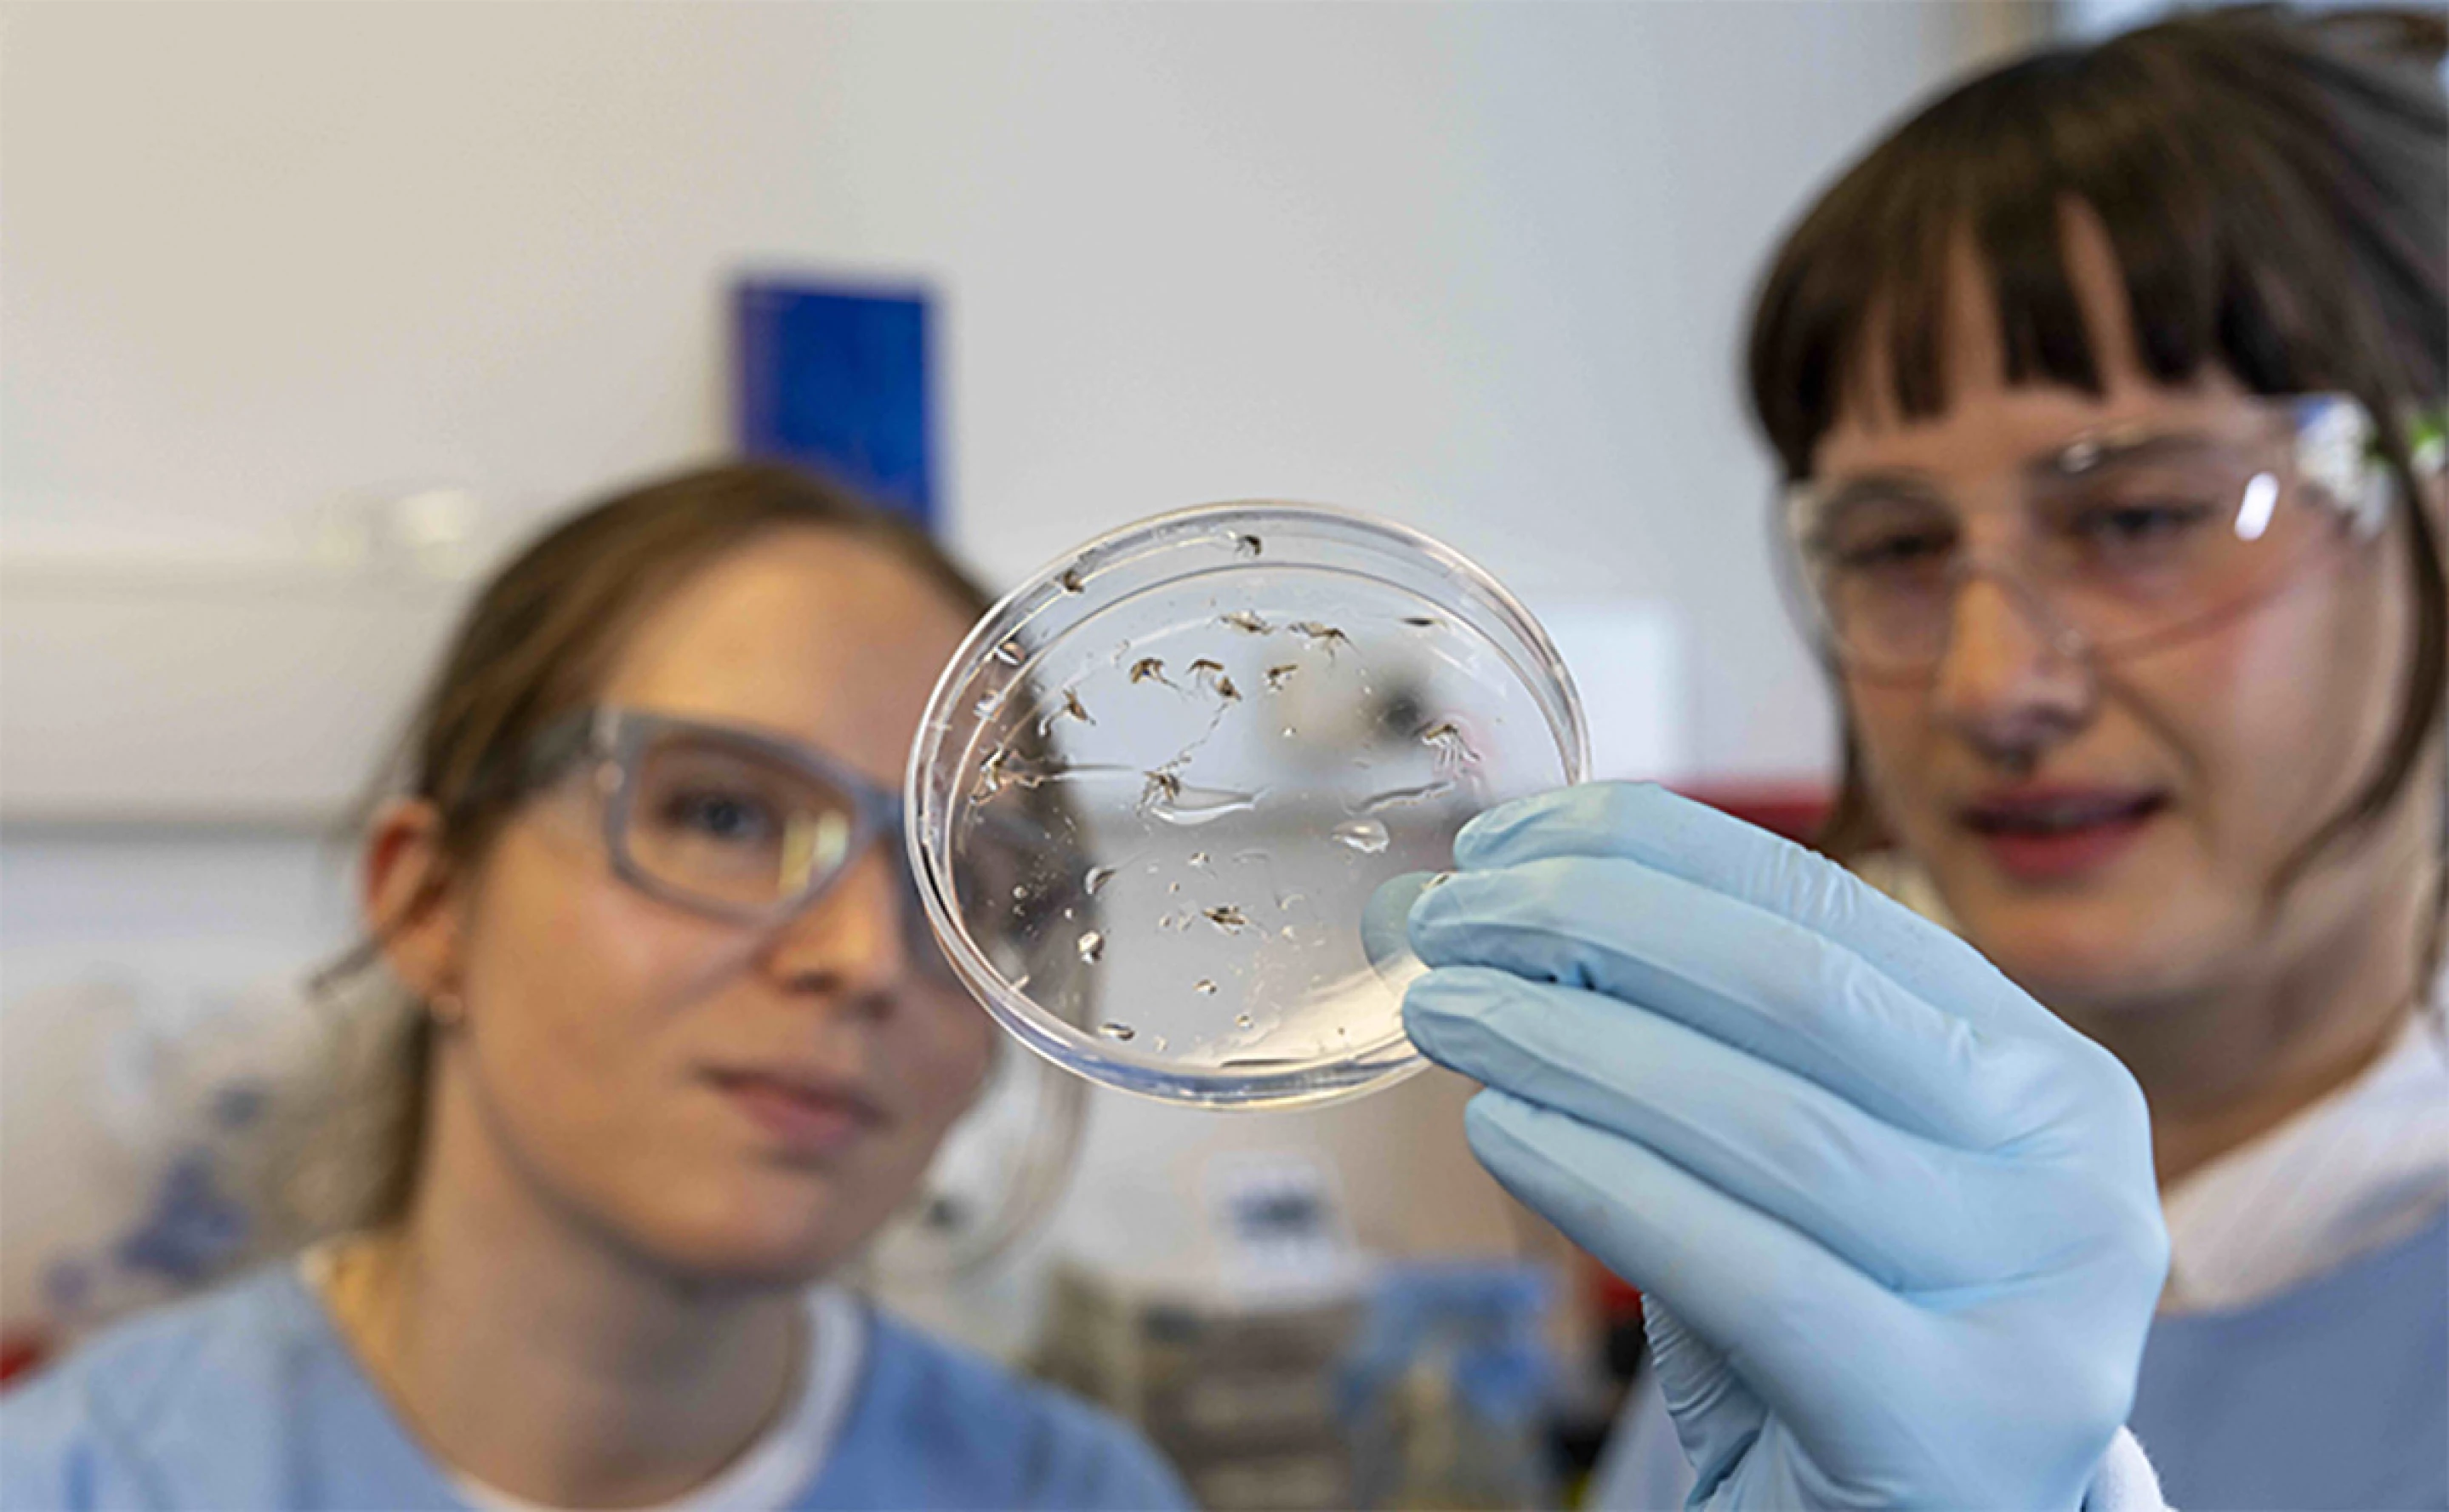

Το εμβόλιο αξιοποιεί ακριβώς αυτές τις περιοχές-κλειδιά της πρωτεϊνικής σύνδεσης, εκπαιδεύοντας το ανοσοποιητικό σύστημα να παράγει αντισώματα που μπλοκάρουν τη διαδικασία αυτή. Σε πειράματα σε ζώα, το αποτέλεσμα ήταν ιδιαίτερα εντυπωσιακό: μείωση της μετάδοσης κατά 99,7%. Αυτό σημαίνει πως η αναπαραγωγή του παρασίτου διακόπτεται στον φορέα (κουνούπι), περιορίζοντας σημαντικά τη διασπορά στους ανθρώπους.
Το εμβόλιο βρίσκεται ακόμα σε προκλινικό στάδιο – απομένει να επιβεβαιωθεί η ασφάλεια και αποτελεσματικότητά του σε κλινικές δοκιμές. Οι ερευνητές τονίζουν ότι τέτοιου τύπου «εμβόλια διακοπής μετάδοσης» είναι συμπληρωματικά στα υπάρχοντα εμβόλια και φάρμακα και, αν συνδυαστούν, μπορούν να μετατρέψουν τη μάχη κατά της ελονοσίας παγκοσμίως.
Leaker: «Εντυπωσιακά τεχνικά χαρακτηριστικά θα έχει το PS6 και το νέο φορητό PlayStation»



Για την καλύτερη εμπειρία σου θα θέλαμε να σε παρακαλέσουμε να το απενεργοποιήσεις κατά την πλοήγησή σου στο site μας ή να προσθέσεις το enternity.gr στις εξαιρέσεις του Ad Blocker.
Με εκτίμηση, Η ομάδα του Enternity